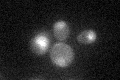
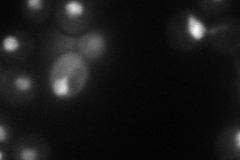
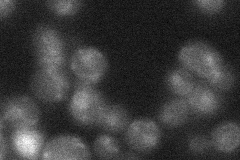
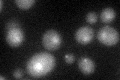

View description
Transcription factor, involved in regulating multidrug resistance and oxidative stress response; forms a heterodimer with Pdr1p; contains a Zn(II)2Cys6 zinc finger domain that interacts with a pleiotropic drug resistance element in vitro
Localization:
Intensity:
Fold change:
Significance:
-
C’ GFP library in SD
nucleus20.09 -
N' NOP1pr-GFP in SD
nucleus48.4538 -
N' TEF2pr-mCherry in SD

punctate,nucleus85.6886 -
N' NATIVEpr-GFP in SD
punctate,nucleus22.3355 -
N' TEF2pr-VC and Cyto-VN in SD

#N/A0 -
C’ GFP library in SD+DTT
nucleus20.761.03No -
C’ GFP library in SD+H2O2

nucleus21.21.05No -
C’ GFP library in Starvation Media

nucleus17.960.89No -
C’ GFP library on the background of Pup2-DaMP

nucleus -
C’ GFP library on the background of CCT mutant

nucleus20.35111.01243No
